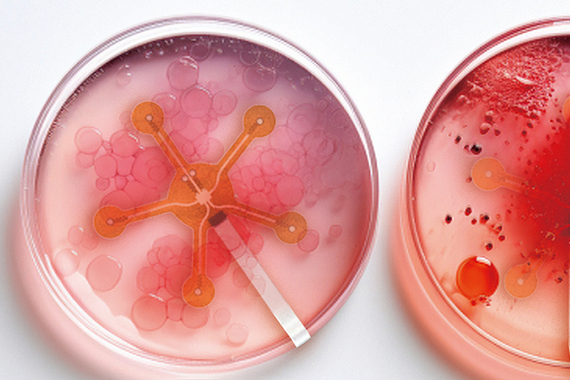
Гибкий мониторинг стволовых клеток

Последние новости

В бассейне Кару на юге Африки впервые обнаружено яйцо синапсиды
13.04 • Анна Новиковская

При гибридизации неандертальские гены активнее распространялись мужчинами, а сапиентные — женщинами
06.04 • Александр Марков

Шерсть домашних кошек напоминает по изотопному составу волосы людей-веганов
02.04 • Елена Устинова

Выбросы углерода вдоль срединно-океанических хребтов — важнейший фактор палеоклимата
25.03 • Владислав Стрекопытов
Видеотека
 52:54
52:54
Ольга Сварник
Фокус, который показывает нам наш мозг
Фестиваль науки NAUKA 0+ • 12.10.2025